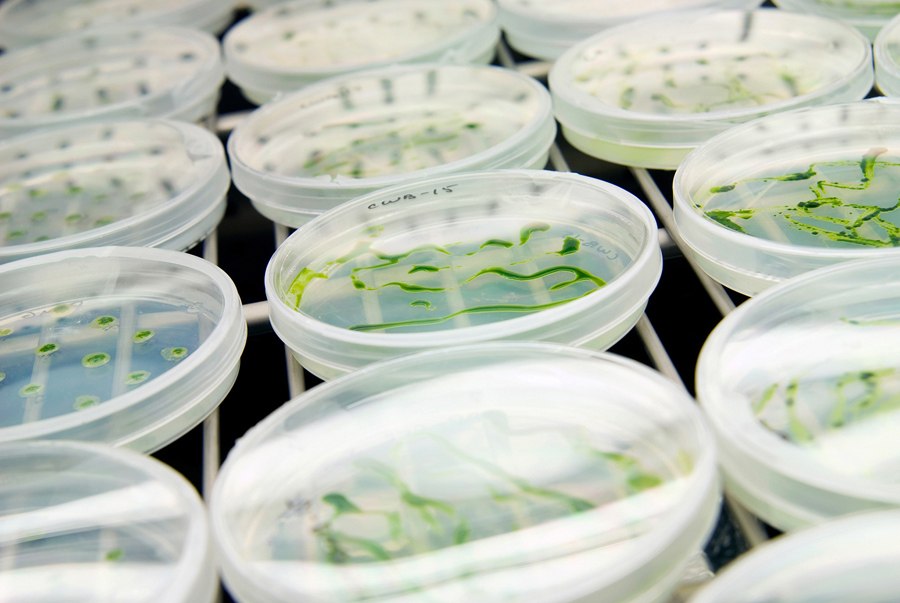

צילום תדמיתי
כיום ישנה חשיבות מכרעת לתדמית של העסק, המפעל או הארגון שלכם. צילומי תדמית חשובים ביותר ונועדו בכדי להציג ולהמחיש את פעילות העסק, להמחיש תהליכי ייצור במפעל של מוצר מסוים וכמובן לשווק את העסק לטובת צבירת לקוחות חדשים. הצילומים יעזרו לאנשי השיווק שלכם לבטא ולמכור את הרעיונות והמטרות של העסק או הארגון. בשווקים התחרותיים של ימינו תוכלו להבליט בעזרת הצילומים או סרטון התדמית את הפעילות והייחודיות של העסק בצורה יצירתית ומקורית. לנצל את הצילומים לפרסום, גיוס משקיעים ועוד..יחד עם אנשי השיווק שלכם נחליט על הצילומים הרצויים בהתאם לסוג העסק והמטרות שלו. נקבע ימי צילום יעילים ואפקטיביים, נכין את השטח לקראת הצילומים מכל הבחינות בכדי ליצור את האווירה המתאימה לצילום. צילומי תדמית נודעו ומתאימים לכל עסק שרוצה למנף את ההצלחה שלו ולקדם את מטרותיו.